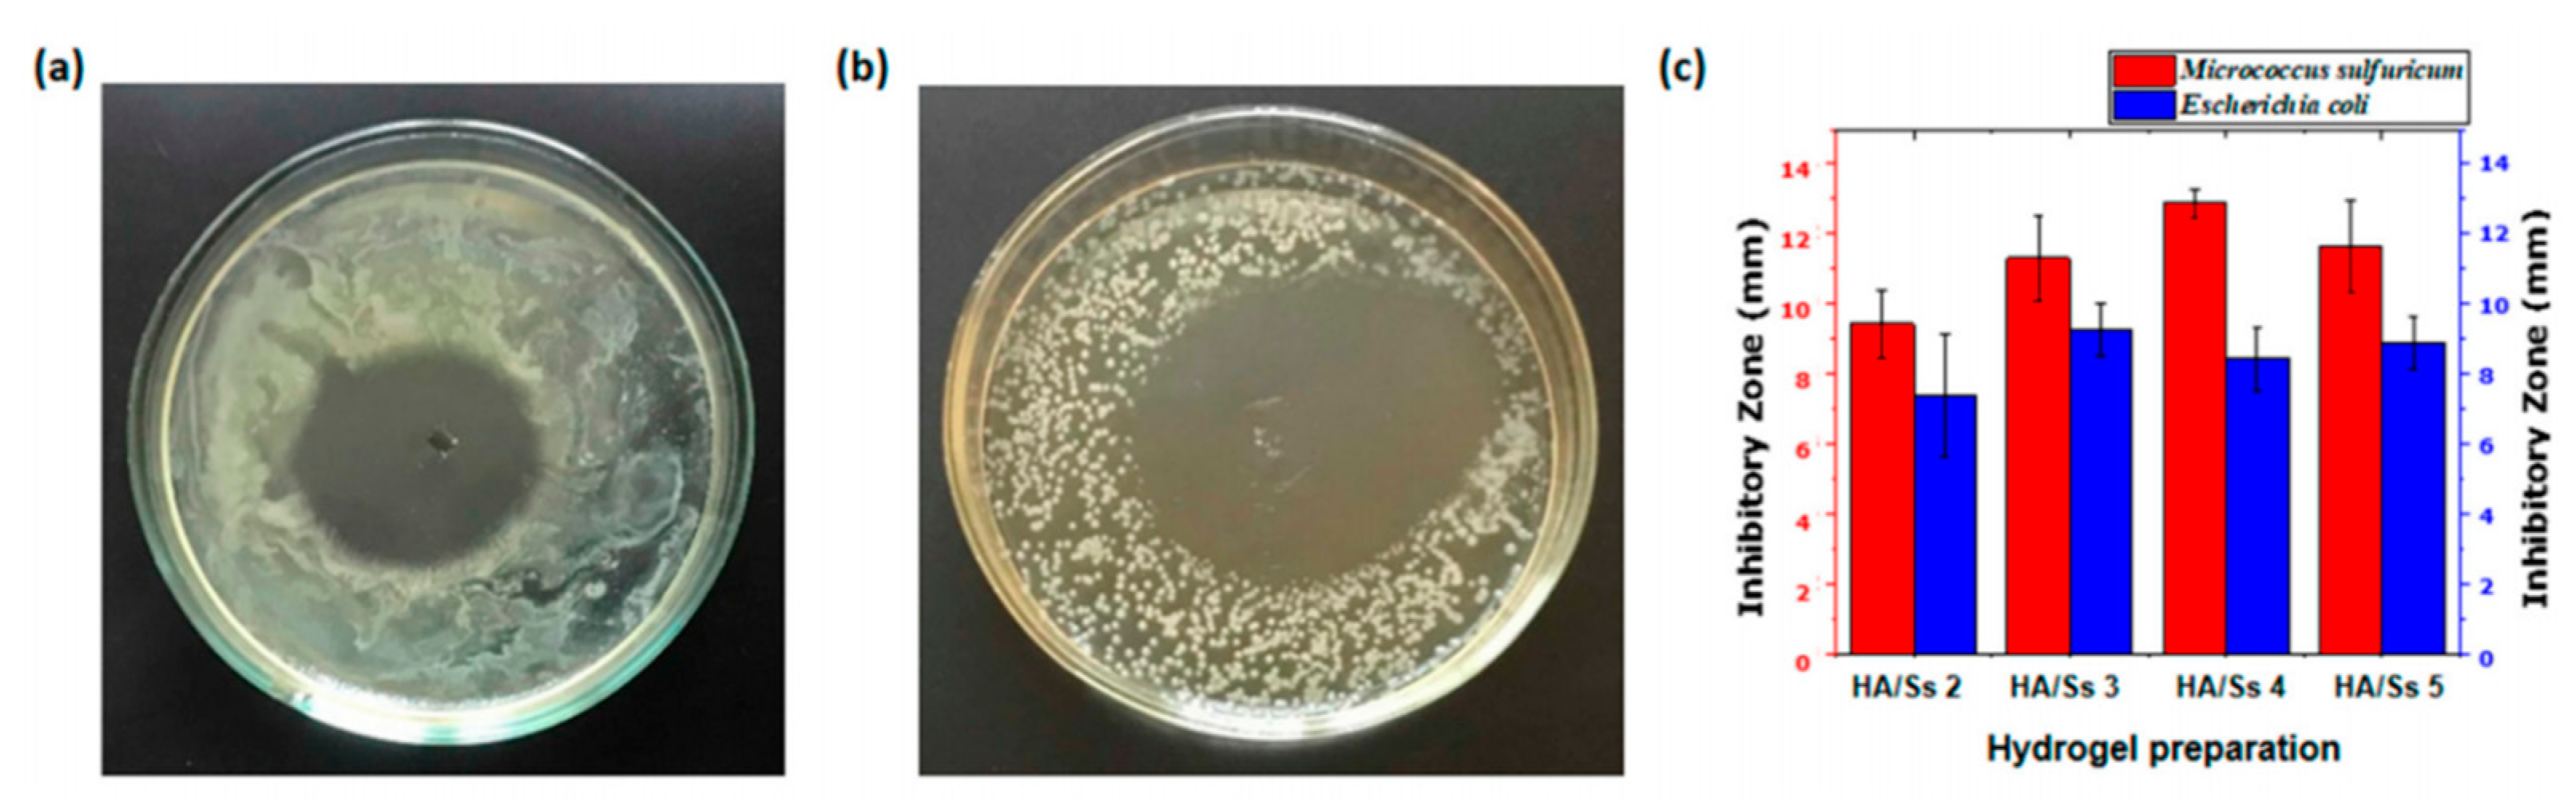
Gels 08 00503 g004

Progress in Antibacterial Hydrogel Dressing
Abstract
:1. Introduction
2. Preparation of Antibacterial Hydrogels
| Synthetic Methods | Species of Hydrogels | Materials | Antimicrobial Capability | Application | Ref. |
|---|---|---|---|---|---|
| Chemical crosslinking | Acacia gum-PVA hydrogel | Acacia gum, PVA, glutaraldehyde, salicylic | Against Bacillus subtilis, P. aeruginosa, E. coli and S. aureus | Wound dressing | [52] |
| Silk fibroin crosslinked glycyrrhizic acid and silver sydrogels | SF, Ag, GA | Against S. aureus, P. aeruginosa | [53] | ||
| PHCI hydrogel | 1,3-dibromo-2-propanol, trans-1,4-cyclohexanediamine | Can adsorb and kill S.aureus and E.coli electrostatically | [54] | ||
| Silk fibroin/chitosan hydrogel | SF, CS, LiBr | Against Bacillus subtilis, methicillin-resistant S. aureus, and E. coli strains with a contact-killing efficacy of 100% | [55] | ||
| Physical crosslinking | Antibacterial chitosan/silver bio-nanocomposite | STPP, chitosan, AgNPs | The antibacterial activity against E. coli and S. aureus lasted for 1 week. | Drug carrier | [56] |
| Polysaccharide based physically crosslinked double-network antibacterial hydrogel | SA, CS, Zn2+ | Against E. coli and S. aureus | Biomedicineureus fields | [57] | |
| AA-Al3+-MGA-[VBIm]Br hydrogel | AA, 1-vinyl-3-butylimidazolium, COOH-modified gum arabic, AlCl3 | Against E. coli, S. aureus, and C. albicans. | Wound dressing | [58] | |
| PVA-TA hydrogel | PVA, TA | Against E. coli and S. aureus | Biomedical fields | [59] | |
| Freezing-thawing cycles | Nano-TiO2/CMCS/PVA composite hydrogel | PVA, CMCS, Nano-TiO2 | Against E. coli and S. aureus | Cosmetics, medical dressings | [60] |
| AgNPs and PVA/CH hydrogel | AgNPs, PVA, CH | Against gram + ve and gram − ve bacteria | Wound dressing | [61] | |
| A polyvinyl alcohol (PVA) hydrogel loaded with guava leaf extract (GLE) | GLE, PVA | Against S. aureus and P. aeruginosa. | [62] | ||
| Uv crosslinking method | PVA-SbQ/MMT composite hydrogel | MMT, PVA-SbQ | against S. aureus was up to 99.95%. | Wound dressing | [63] |
| Solution polymerization | ZnO@GDM hydrogel | ZnO, GelMA, DMAA, MAA | Against E.coli reached more than 98% | Biomedical fields | [64] |
| Poly(DMA-co-AAc) hydrogel | DMA, AAc, ammonium persulfate | Inhibit the growth of S. aureus. | Antibacterial materials | [65] | |
| Photoinduction | Hydrogel containing silver nanoparticles | AgNO3, MDEA, acrylamide, bis-AAm | Fully inhibition of the growth of Acinetobacter johnsonii and E. coli. | Wound dressing | [66] |
| Antibacterial acrylamide hydrogels containing silver | Acrylamide, silver nitrate, trisodium citrate dihydrate,1-[4-(2-hydroxy-ethoxy)phenyl]-2- hydroxy-2-methyl-1-propane-1-one | Against pathogenic E. coli O157:H7, S. aureus, and non-pathogenic E. coli K-12 | Water-based applications | [67] | |
| Chitosan-PEG hydrogels | Chitosan derivatives, PEG | 100% inhibition of the E. coli and S. aureus | Bio-functional materials | [68] | |
| Coacervation | CS@CMC@ZeoliteP@KDF hydrogel | ZeoliteP, KDF, CMC, CS | Inhibit the growth of E.coli and S. aureus. | Bacteriostatic agent | [69] |
| Chemical–physical crosslinking | DR-CC hydrogel | Carboxylated chitosan, diazoresin | Can kill E. coli and S.aureus. | Wound dressing | [70] |
| β-CD/PEI/PVA composite hydrogels | β-CD, PVA, PEI | Against E. coli and S. aureus | [71] | ||
| Lignin hydrogels | SBMA, lignin-MA | Antimicrobial performance of 94.8% reduction of E. coli and 95.7% of S. aureus. | Biomedical fields | [72] | |
| Chitosan/PV A-based hydrogels | CS, PVA | Against S.aureus and K. pneumonia | Oral dressing | [73] | |
| Free radical crosslinking polymerization | P(MMA-co-MAA)/Ag nanocomposite | MMA, MAA, AgNPs | Against S. aureus and B. subtilis. | Smart material | [74] |
| Poly(N-[3-(dimethylaminopropyl)] methacrylamide) hydrogels | Cetyltrimethylammonium bromide, KPS, BIS | Against E. coli | Antimicrobial agent | [75] | |
| Tea Ag nanocomposite hydrogels | Acrylamide, MBA, TEMDA, KPS | Against E. coli and S. aureus. | Wound dressing | [76] | |
| D/SD-g-PAA-based hydrogels | MBA, AA | Can kill S. aureus and E. coli and Klebsiella spp. | [77] | ||
| Gamma-ray irradiation | Metronidazole/poly(acrylic acid) hydrogel | Metronidazole, poly(acrylic acid) | Against E. coli, S. aureus, S. mutans. | Wound dressing | [78] |
| P-PVA hydrogel | phosphorus-containing PVA | Against various fungi and bacteria | Biological fields | [79] | |
| Poly(Agar-co-AAc) hydrogels | AAc, agar | Against E. coli and S. aureus. | Wound dressing | [80] | |
| Polyvinyl pyrrolidone/carboxymethyl cellulose hydrogels | Polyvinyl pyrrolidone, carboxymethyl cellulose, AgNPs | Against bacterial, S. aureus, P. aeruginosa, E. coli and Candida albicans | Therapeutic dressing | [81] | |
| Reverse emulsification- diffusion | Alginate nano hydrogel | Alginate, iron (II)-chloride, sodium lactate | Against E. coli and S. aureus. | Smart textile | [82] |
3. Performance of Antibacterial Hydrogels
3.1. Antibacterial Properties
3.2. Water Absorption and Swelling Capacity
3.3. Drug Release Properties
3.4. Permeability
3.5. Biocompatibility
4. Classification and Mechanism of Antibacterial Hydrogels
4.1. Antibacterial Hydrogels Containing Inorganic Nanoparticles
4.1.1. Antibacterial Hydrogel Containing Silver Nanoparticles
4.1.2. Antibacterial Hydrogel Containing Zinc Oxide Nanoparticles
4.1.3. Antibacterial Hydrogel Containing Titanium Dioxide Nanoparticles
4.1.4. Antibacterial Hydrogel Containing Other Nanoparticles
4.2. Antibiotic-Loaded Antibacterial Hydrogels
4.2.1. Aminoglycoside-Loaded Antibacterial Hydrogels
4.2.2. Glycopeptides-Loaded Antibacterial Hydrogels
4.2.3. Quinolones-Loaded Antibacterial Hydrogels
4.3. Hydrogels with Inherent Antibacterial Activity
4.3.1. Antimicrobial Peptide Hydrogel
4.3.2. Chitosan Antibacterial Hydrogel
4.3.3. Amphoteric Ion Antibacterial Hydrogel
4.4. Photosensitive Antibacterial Hydrogel
4.5. Hydrogels with Synergetic Effects
5. Summary and Prospect
Author Contributions
Funding
Institutional Review Board Statement
Informed Consent Statement
Data Availability Statement
Acknowledgments
Conflicts of Interest
References
- Hu, J.H.; Zhu, Q.G.; Sun, H.J.; Gao, W. Classification and characteristics of medical dressings. Pharm. J. Chin. People’s Lib. Army 2000, 16, 147–148, 167. [Google Scholar]
- Liu, C.; Han, H.; Ye, T.T.; Wu, D.Q. Preparation and antibacterial properties of hydrogel-based medical cotton dressing. China Text. Lead. 2021, 64–68. [Google Scholar] [CrossRef]
- Werdin, F.; Tennenhaus, M.; Schaller, H.E.; Rennekampff, H.O. Evidence-based management strategies for treatment of chronic wounds. Eplasty 2009, 9, 169–179. [Google Scholar]
- Centers for Disease Control and Prevention. National Diabetes Fact Sheet: National Estimates and General Information on Diabetes and Prediabetes in the United States, 2011; U.S. Department of Health and Human Services, Centers for Disease Control and Prevention: Atlanta, GA, USA, 2011; Volume 201, pp. 2568–2569.
- Eo, S.R.; Kim, Y.S.; Cho, S.H. Vacuum-assisted closure improves the incorporation of artificial dermis in soft tissue defects: Terudermis® and Pelnac®. Int. Wound J. 2011, 8, 261–267. [Google Scholar] [CrossRef] [PubMed]
- Smith, D.M.; Snow, D.E.; Rees, E.; Zischkau, A.M.; Hanson, J.D.; Wolcott, R.; Sun, Y.; White, J.; Kumar, S.; Dowd, S.E. Evaluation of the bacterial diversity of Pressure ulcers using b TEFAP pyrosequencing. BMC Med. Genom. 2010, 21, 41–45. [Google Scholar] [CrossRef] [PubMed]
- Selig, H.F.; Lumenta, D.B.; Giretzlehner, M.; Jeschke, M.G.; Upton, D.; Kamolz, L.P. The properties of an “ideal” burn wound dressing-What do we need in daily clinical practice? Results of a worldwide online survey among burn care specialists. Burns 2012, 38, 960–966. [Google Scholar] [CrossRef] [PubMed]
- Andreu, V.; Mendoza, G.; Arruebo, M.; Irusta, S. Smart dressings based on nanostructured fibers containing natural origin antimicrobial, anti-inflammatory, and regenerative compounds. Materials 2015, 8, 5154–5193. [Google Scholar] [CrossRef]
- Jayakumar, R.; Prabaharan, M.; Kumar, P.T.S.; Nair, S.V.; Tamura, H.V.H. Biomaterials based on chitin and chitosan in wound dressing applications. Biotechnol. Adv. 2011, 29, 322–337. [Google Scholar] [CrossRef] [PubMed]
- Phaechamud, T.; Issarayungyuen, P.; Pichayakorn, W. Gentamicin sulfate-loaded porous natural rubber films for wound dressing. Int. J. Biol. Macromol. 2016, 85, 634–644. [Google Scholar] [CrossRef]
- Borges, F.A.; Drago, B.C.; Luís, O.B.; Barros, N.; Pegorin, G.S.; Scontri, M.; Mussagy, C.U.; Ribeiro, M.C.; Milori, D.M.B.P.; Morais, C.P.; et al. Metronidazole-loaded gold nanoparticles in natural rubber latex as a potential wound dressing. Int. J. Biol. Macromol. 2022, 211, 568–579. [Google Scholar] [CrossRef]
- Watthanaphanit, A.; Rujiravanit, R. Sericin-binded-deprotenized natural rubber film containing chitin whiskers as elasto-gel dressing. Int. J. Biol. Macromol. 2017, 101, 417–426. [Google Scholar] [CrossRef] [PubMed]
- Qin, J.; Guo, J.; Xu, Q.; Zheng, Z.Q.; Mao, H.L.; Yan, F. Synthesis of pyrrolidinium-type poly(ionic liquid) membranes for antibacterial applications. ACS. Appl. Mater. Interfaces 2017, 9, 10504–10511. [Google Scholar] [CrossRef] [PubMed]
- Luo, Z.; Cui, H.; Guo, J.; Yao, J.R.; Fang, X.; Yan, F. Poly(ionic liquid)/Ce-based antimicrobial nanofibrous membrane for blocking drug-resistance dissemination from MRSA-Infected wounds. ADV Funct. Mater. 2021, 31, 2100336. [Google Scholar] [CrossRef]
- Chaiarwut, S.; Ekabutr, P.; Chuysinuan, P.; Chanamuangkon, T.; Supaphol, P. Surface immobilization of PCL electrospun nanofibers with pexiganan for wound dressing. J. Polym. Res. 2021, 28, 344. [Google Scholar] [CrossRef]
- Peng, Y.; Ma, Y.; Bao, Y.; Liu, Z.L.; Chen, L.; Dai, F.Y.; Li, Z. Electrospun PLGA/SF/artemisinin composite nanofibrous membranes for wound dressing. Int. J. Biol. Macromol. 2021, 183, 68–78. [Google Scholar] [CrossRef]
- Ghosal, K.; Agatemor, C.; Špitálsky, Z.; Thomas, S.; Kny, E. Electrospinning tissue engineering and wound dressing scaffolds from polymer-titanium dioxide nano-composites. Chem. Eng. J. 2019, 358, 1262–1278. [Google Scholar] [CrossRef]
- Wang, H.B.; Zhu, H.; Fu, W.G.; Zhang, Y.Y.; Xu, B.; Gao, F.; Cao, Z.Q.; Liu, W.G. A high strength self-healable antibacterial and anti-inflammatory supramolecular polymer hydrogel. Macromol. Rapid. Comm. 2017, 38, 1600695. [Google Scholar] [CrossRef] [PubMed]
- Wang, K.; Wang, J.; Li, L.; Xu, L.Q.; Feng, N.; Wang, Y.; Fei, X.; Tian, J.; Li, Y. Synthesis of a novel anti-freezing, non-drying antibacterial hydrogel dressing by one-pot method. Chem. Eng. J. 2019, 372, 216–225. [Google Scholar] [CrossRef]
- Wichterle, O.; Lim, D. Hydrophilic gels for biological use. Nature 1960, 185, 117–118. [Google Scholar] [CrossRef]
- Rowland, M.J.; Atgie, M.; Hoogland, D.; Scherman, O.A. Preparation and supramolecular recognition of multivalent peptide–polysaccharide conjugates by cucurbit [8]uril in hydrogel formation. Biomacromolecules 2015, 16, 2436–2443. [Google Scholar] [CrossRef]
- Liu, L.; Feng, X.; Pei, Y.; Wang, J.Z.; Ding, J.X.; Chen, L. α-Cyclodextrin concentration-controlled thermo-sensitive supramolecular hydrogels. Mat. Sci. Eng. C 2018, 82, 25–28. [Google Scholar] [CrossRef]
- El-Sherbiny, I.M.; Hamid, M.A.; Rashad, M.; Ali, A.S.M.; Azab, Y. New calcareous soil–alginate composites for efficient uptake of Fe (III), Mn (II) and As (V) from water. Carbohyd. Polym. 2013, 96, 450–459. [Google Scholar] [CrossRef]
- Hunter, A.M.; Grigson, C.; Wade, A. Influence of topically applied menthol cooling gel on soft tissue thermodynamics and arterial and cutaneous blood flow at rest. Int. J. Sports Phys. Ther. 2018, 13, 483–492. [Google Scholar] [CrossRef]
- Zhang, Y.; An, D.; Pardo, Y.; Chiu, A.; Song, W.; Liu, Q.; Zhou, F.; McDonough, S.P.; Ma, M. High-water-content and resilient PEG-containing hydrogels with low fibrotic response. Acta Biomater. 2017, 53, 100–108. [Google Scholar] [CrossRef] [PubMed]
- Patenaude, M.; Smeets, N.M.; Hoare, T. Designing injectable, covalently cross-linked hydrogels for biomedical applications. Macromol. Rapid Commun. 2014, 35, 598–617. [Google Scholar] [CrossRef]
- Ng, V.W.; Chan, J.M.; Sardon, H.; Ono, R.J.; García, J.M.; Yang, Y.Y.; Hedrick, J.L. Antimicrobial hydrogels: A new weapon in the arsenal against multidrug-resistant infections. Adv. Drug Deliv. Rev. 2014, 78, 46–62. [Google Scholar] [CrossRef]
- Noimark, S.; Dunnill, C.W.; Wilson, M.; Parkin, I.P. The role of surfaces in catheter-associated infections. Chem. Soc. Rev. 2009, 38, 3435–3448. [Google Scholar] [CrossRef]
- Hetrick, E.M.; Schoenfisch, M.H. Reducing implant-related infections: Active release strategies. Chem. Soc. Rev. 2006, 35, 780–789. [Google Scholar] [CrossRef] [PubMed]
- Shea, L.D.; Woodruff, T.K.; Shikanov, A. Bioengineering the ovarian follicle microenvironment. Annu. Rev. Biomed. Eng. 2014, 16, 29–52. [Google Scholar] [CrossRef] [PubMed]
- Liu, S.F.; Gu, Z.Y. Application of temperature-sensitive hydrogels to the development of intelligent fabrics. J. Text. Inst. 2007, 11, 139–143. [Google Scholar]
- Wu, M.Q.; Hua, J.C.; He, G.D.; Li, Z.; Gong, J.X.; Zhang, J.F. Application of hydrogels in textile industry. Dye. Finish. 2016, 42, 52–55. [Google Scholar]
- Li, H.N.; Yang, J.; Hu, X.N.; Liang, J.; Fan, Y.J.; Zhang, X.D. Superabsorbent polysaccharide hydrogels based on pullulan derivate as antibacterial release wound dressing. J. Biomed. Mater. Res. A 2011, 98, 31–39. [Google Scholar] [CrossRef]
- Kumaraswamy, S.; Francis, S.; Somashekarappa, H.M. Gamma irradiation synthesis of Ag/PVA hydrogels and its antibacterial activity. Mater. Today Proc. 2016, 3, 1792–1798. [Google Scholar]
- Xu, D.D.; Huang, J.C.; Zhao, D.; Ding, B.B.; Zhang, L.N.; Cai, J. High-flexibility, high-toughness double-cross-linked chitin hydrogels by sequential chemical and physical cross-linkings. Adv. Mater. 2016, 28, 5844–5849. [Google Scholar] [CrossRef]
- Yang, K.R.; Han, Q.; Chen, B.P.; Zheng, Y.H.; Zhang, K.S.; Li, Q.; Wang, J.C. Antimicrobial hydrogels: Promising materials for medical application. Int. J. Nanomed. 2018, 13, 2217. [Google Scholar] [CrossRef]
- Song, T.; Xi, Y.J.; Du, J.Z. Antibacterial hydrogels incoporated with poly(glutamic acid)-based vesicles. Acta Polym. Sin. 2018, 119–128. [Google Scholar] [CrossRef]
- Zhang, L.; Yuan, H.B.; Chen, L.; Hong, F. Study on properties of bacterial nanocellulose-based antibacterial hydrogel composite dressings. J. Fuel Cell Sci. Technol. 2019, 27, 31–38, 58. [Google Scholar]
- Xiao, L.Z.; Hui, F.; Tian, T.G.; Yan, R.Y.; Xin, J.W.; Zhao, X.Y.; Jiang, Y.N.; Zhang, Z.; Kuang, Y.L.; Li, N.; et al. A novel conductive antibacterial nanocomposite hydrogel dressing for healing of severely infected wounds. Front. Chem. 2021, 9, 787886. [Google Scholar] [CrossRef] [PubMed]
- Khashan, K.S.; Sulaiman, G.M.; Abdulameer, F.A.; Ibrahem, M.A.; Al-Muhimeed, T.; AlObaid, A.A. Antibacterial activity of TiO2 nanoparticles prepared by one-step laser ablation in liquid. Appl. Sci. 2021, 11, 4623. [Google Scholar] [CrossRef]
- Yan, J.; Ji, Y.; Huang, M.; Tao, L.; Liu, Y.H.; Lü, S.Y.; Liu, M.Z. Nucleobase-inspired self-adhesive and inherently antibacterial hydrogel for wound dressing. ACS Mater. Lett. 2020, 2, 1375–1380. [Google Scholar] [CrossRef]
- Wang, K.; Wang, J.; Li, L.; Xu, L.Q.; Feng, N.; Wang, Y.; Fei, X.; Tian, J.; Li, Y. Novel nonreleasing antibacterial hydrogel dressing by a one-pot method. ACS Biomater. Sci. Eng. 2020, 6, 1259–1268. [Google Scholar] [CrossRef] [PubMed]
- Caló, E.; Khutoryanskiy, V.V. Biomedical applications of hydrogels: A review of patents and commercial products. Eur. Polym. J. 2015, 65, 252–267. [Google Scholar] [CrossRef]
- Tian, R.; Qiu, X.Y.; Yuan, P.Y.; Lin, K.; Bai, K.Y.; Liu, S.Y.; Chen, X. Fabrication of self-healing hydrogels with on-demand antimicrobial activity and sustained biomolecule release for infected skin regeneration. ACS Appl. Mater. Interfaces 2018, 10, 17018–17027. [Google Scholar] [CrossRef] [PubMed]
- Ullah, F.; Othman, M.B.H.; Javed, F.; Ahmad, Z.; Akil, H.M. Classification, processing and application of hydrogels: A review. Mater. Sci. Eng. C 2015, 57, 414–433. [Google Scholar] [CrossRef]
- Li, X.Q.; Jiang, Y.J.; Wang, F.; Fan, Z.J.; Wang, H.N.; Tao, C.H.; Wang, Z.F. Preparation of polyurethane/polyvinyl alcohol hydrogel and its performance enhancement via compositing with silver particles. RSC Adv. 2017, 7, 46480–46485. [Google Scholar] [CrossRef]
- Shin, B.; Kim, J.J.; Vales, T.P.; Yang, S.K.; Kim, J.K.; Sohn, H.; Kim, H.J. Thermoresponsive drug controlled release from chitosan-based hydrogel embedded with poly(N-isopropylacrylamide) nanogels. J. Polym. Sci. Polym. Chem. 2018, 56, 1907–1914. [Google Scholar] [CrossRef]
- Fajardo, A.R.; Fávaro, S.L.; Rubira, A.F.; Muniz, E.C. Dual-network hydrogels based on chemically and physically crosslinked chitosan/chondroitin sulfate. React. Funct. Polym. 2013, 73, 1662–1671. [Google Scholar] [CrossRef]
- Alcântara, M.T.S.; Lincopan, N.; Santos, P.M.; Ramirez, P.A.; Brant, A.J.C.; Riella, H.G.; Lugão, A.B. Simultaneous hydrogel crosslinking and silver nanoparticle formation by using ionizing radiation to obtain antimicrobial hydrogels. Radiat. Phys. Chem. 2020, 169, 108777. [Google Scholar] [CrossRef]
- Wang, J.G.; Li, Y.Z.; Gao, Y.F.; Xie, Z.F.; Zhou, M.H.; He, Y.Y.; Wu, H.; Zhou, W.Y.; Dong, X.M.; Yang, Z.H.; et al. Cinnamon oil-loaded composite emulsion hydrogels with antibacterial activity prepared using concentrated emulsion templates. Ind. Crop. Prod. 2018, 112, 281–289. [Google Scholar] [CrossRef]
- Ma, Y.F.; Zhao, Z.H.; Tang, B.Y.; Wu, Y.G.; Zhang, H.L. Facile preparation of polymer-grafted halloysite nanotubes via a redox system: A novel approach to construct antibacterial hydrogel. Macromol. Res. 2020, 28, 948–952. [Google Scholar] [CrossRef]
- Song, T.L.; Ynag, J.; Lin, J.H.; Liu, Y.L.; Tao, H.B.; Huang, Z.B.; Huang, X.M.; Xie, X.B. Preparation and properties of antibacterial hydrogel. Ind. Microbiol. 2019, 49, 54–57. [Google Scholar]
- Zhang, F.; Yin, C.J.; Qi, X.J.; Guo, C.L.; Wu, X.C. Silk fibroin crosslinked glycyrrhizic acid and silver hydrogels for accelerated bacteria-infected wound healing. Macromol. Biosci. 2022, 22, 2100407. [Google Scholar] [CrossRef]
- Cheng, S.Y.; Wang, H.; Pan, X.H.; Zhang, C.; Zhang, K.X.; Chen, Z.L.; Dong, W.; Xie, A.M.; Qi, X.L. Dendritic hydrogels with robust inherent antibacterial properties for promoting bacteria-infected wound healing. ACS Appl. Mater. Interfaces 2022, 14, 11144–11155. [Google Scholar] [CrossRef]
- Xu, Z.P.; Chen, T.Y.; Zhang, K.Q.; Meng, K.; Zhao, H.J. Silk fibroin/chitosan hydrogel with antibacterial, hemostatic and sustained drug-release activities. Polym. Int. 2021, 70, 1741–1751. [Google Scholar] [CrossRef]
- Yadollahi, M.; Farhoudian, S.; Namazi, H. One-pot synthesis of antibacterial chitosan/silver bio-nanocomposite hydrogel beads as drug delivery systems. Int. J. Biol. Macromol. 2015, 79, 37–43. [Google Scholar] [CrossRef] [PubMed]
- Shi, C.; Yang, F.M.; Wang, H.B.; Wang, Y.X.; Wang, Z.C.; Pan, S.H.; Chen, J.D. Construction of polysaccharide based physically crosslinked double-network antibacterial hydroge. Mater. Lett. 2022, 316, 132048. [Google Scholar] [CrossRef]
- Li, D.R.; Fei, X.; Wang, K.; Xu, L.Q.; Wang, Y.; Tian, J.; Li, Y. A novel self-healing triple physical cross-linked hydrogel for antibacterial dressing. J. Mater. Chem. B 2021, 9, 6844–6855. [Google Scholar] [CrossRef]
- He, G.H.; Cao, J.L.; Wang, C.; Fan, L.H.; Yin, Y.H.; Cai, W.Q.; Tao, S.X. Physically cross-linked hydrogels with excellent self-healing, moldability, antibacterial activities and adjustable mechanical properties. J. Wuhan Univ. Technol.-Mater. Sci. Ed. 2019, 34, 1484–1494. [Google Scholar] [CrossRef]
- Li, Y.S.; Han, Y.; Qin, J.T.; Song, Z.Y.; Cai, H.H.; Du, J.F.; Sun, S.F.; Liu, Y. Photosensitive antibacterial and cytotoxicity performances of a TiO2/carboxymethyl chitosan/poly(vinyl alcohol) nanocomposite hydrogel by in situ radiation construction. J. Appl. Polym. Sci. 2016, 133, 44150. [Google Scholar]
- Kumar, A.; Behl, T.; Chadha, S. Synthesis of physically crosslinked PVA/Chitosan loaded silver nanoparticles hydrogels with tunable mechanical properties and antibacterial effects. Int. J. Biol. Macromol. 2020, 149, 1262–1274. [Google Scholar] [CrossRef]
- Waresindo, W.X.; Luthfianti, H.R.; Edikresnha, D.; Suciati, A.; Noor, F.A.; Khairurrijal, K. A freeze-thaw PVA hydrogel loaded with guava leaf extract: Physical and antibacterial properties. RSC Adv. 2021, 11, 30156–30171. [Google Scholar] [CrossRef] [PubMed]
- Dong, J.C.; Liu, W.; Chen, Y.J.; Wang, Q.Q. Prearation and characterization of photoantimicrobial PVA-SbQ/MMT composite hydrogel. J. Mater. Eng. 2017, 45, 156–159. [Google Scholar]
- Deng, W.C.; Tan, J.X.; Tian, Y.; Liang, Z.H.; Guan, Y.J.; Zhou, Z.N. Preparation of ZnO doped piezoelectric hydrogel and its antibacterial mechanism. China Surf. Eng. 2022, 35, 1–8. [Google Scholar]
- Nakan, U.; Bieerkehazhi, S.; Tolkyn, B.; Mun, G.A.; Assanov, M.; Nursultanov, M.E.; Rakhmetullayeva, R.K.; Toshtay, K.; Negim, E.; Ydyrys, A. Synthesis, characterization and antibacterial application of copolymers based on N, N-Dimethyl acrylamide and acrylic acid. Materials 2021, 14, 6191. [Google Scholar] [CrossRef]
- Staneva, D.; Vasileva-Tonkova, E.; Grabchev, I. Preparation, characterization, and antibacterial activity of composite material: Cotton fabric/hydrogel/silver nanoparticles. Int. J. Polym. Anal. Ch. 2016, 22, 104–111. [Google Scholar] [CrossRef]
- Uygun, M.; Kahveci, M.U.; Odaci, D.; Timur, S.; Yagci, Y. Antibacterial acrylamide hydrogels containing silver nanoparticles by simultaneous photoinduced free radical polymerization and electron transfer processes. Macromol. Chem. Phys. 2009, 210, 1867–1875. [Google Scholar] [CrossRef]
- Sautrot-Ba, P.; Razza, N.; Breloy, L.; Andaloussi, S.A.; Chiappone, A.; Sangermano, M.; Hélary, C.; Belbeckouche, S.; Coradin, T.; Versace, D.-L. Photoinduced chitosan-PEG hydrogels with long-term antibacterial properties. J. Mater. Chem. B 2019, 7, 6526–6538. [Google Scholar] [CrossRef]
- Guo, X.W.; Li, Y.Y.; Wang, X.L.; Yang, Z.X.; Chen, N.C.; Xie, Q.L. Prearation of pH-sensitivity hydrogel microspheres and potassium difformate sustained-release and antibacterial performance analysis. J. Mater. Eng. 2021, 49, 142–149. [Google Scholar]
- Zhang, H. Preparation of Zinc-Based/Polyquaternary Ammonium Antibacterial Hydrogel and Its Application as Wound Dressing; Qingdao University: Qingdao, China, 2019. [Google Scholar]
- Liu, D.; Qiu, J.J.; Xu, R.; Liu, J.Y.; Ouyang, L.P.; Qian, S.; Qiao, Y.Q.; Liu, X.Y. β-CD/PEI/PVA composite hydrogels with superior self-healing ability and antibacterial activity for wound healing. Compos. Part B-Eng. 2022, 238, 109921. [Google Scholar] [CrossRef]
- Xu, C.; Liu, L.Y.; Renneckar, S.; Jiang, F. Chemically and physically crosslinked lignin hydrogels with antifouling and antimicrobial properties. Ind. Crop. Prod. 2021, 170, 113759. [Google Scholar] [CrossRef]
- Suflet, D.M.; Popescu, I.; Pelin, I.M.; Ichim, D.L.; Daraba, O.M.; Constantin, M.; Fundueanu, G. Dual cross-linked chitosan/pva hydrogels containing silver nanoparticles with antimicrobial properties. Pharmaceutics 2021, 13, 1461. [Google Scholar] [CrossRef] [PubMed]
- Wei, Q.B.; Fu, F.; Zhang, Y.Q.; Tang, L. Preparation, characterization, and antibacterial properties of pH-responsive P(MMA-co-MAA)/silver nanocomposite hydrogels. J. Polym. Res. 2014, 21, 349. [Google Scholar] [CrossRef]
- Sabah, K.C.; Yalçın, B.; Şimşek, C.; Gürsel, Y.H.; Erbil, C. Improved mechanical properties of antimicrobial poly(N-[3-(dimethylaminopropyl)] methacrylamide) hydrogels prepared by free radical polymerization in the presence of cetyltrimethylammonium bromide as a lyotropic liquid crystal template. Soft Matter 2022, 18, 4156–4166. [Google Scholar] [CrossRef] [PubMed]
- Jayaramudu, T.; Varaprasad, K.; Raghavendra, G.M.; Sadiku, E.R.; Raju, K.M. Green synthesis of tea Ag nanocomposite hydrogels via mint leaf extraction for effective antibacterial activity. J. Biomat. Sci.-Polym. E 2017, 28, 1588–1602. [Google Scholar] [CrossRef] [PubMed]
- Virych, P.; Nadtoka, O.; Doroschuk, V.; Lelyushok, S.; Chumachenko, V.; Bezugla, T.; Kutsevol, N. Cefuroxime-loaded hydrogels for prevention and treatment of bacterial contamination of open wounds. Int. J. Polym. Sci. 2021, 2021, 4935642. [Google Scholar] [CrossRef]
- Jeong, J.; Park, J.S.; Kim, E.J.; Jeong, S.I.; Lee, J.Y.; Lim, Y.M. Preparation of radiation cross-linked poly(acrylic acid) hydrogel containing metronidazole with enhanced antibacterial activity. Int. J. Mol. Sci. 2019, 21, 187. [Google Scholar] [CrossRef] [PubMed]
- El-Mohdy, A.; Aly, H.M. Characterization, properties and antimicrobial activity of radiation induced phosphorus-containing PVA hydrogels. Arab. J. Sci. Eng. 2022, 1–11. [Google Scholar] [CrossRef]
- Bustamante-Torres, M.; Pino-Ramos, V.H.; Romero-Fierro, D.; Hidalgo-Bonilla, S.P.; Magaña, H.; Bucio, E. Synthesis and antimicrobial properties of highly cross-linked pH-sensitive hydrogels through gamma radiation. Polymers 2021, 13, 2223. [Google Scholar] [CrossRef]
- Singh, R.; Singh, A. Radiation synthesis of hydrogels with silver nanoparticles for use as an antimicrobial burn wound dressing. Polym. Sci. Ser. B 2022, 64, 188–197. [Google Scholar] [CrossRef]
- Salamatipour, N.; Hemmatinejad, N.; Bashari, A. Synthesis of redox-light responsive alginate nano hydrogel to produce smart textile. Fibers Polym. 2019, 20, 690–697. [Google Scholar] [CrossRef]
- Chang, C.; Chen, S.J.; Duan, S.X.; Zhang, Z.N.; Han, X.H. Research status and application prospects of biomedical hydrogel dressings. China Text. Lead. 2018, 5, 47–51. [Google Scholar]
- Gharibi, R.; Shaker, A.; Rezapour, A.; Agarwal, S. Antibacterial and biocompatible hydrogel dressing based on gelatin-and castor-oil-derived biocidal agent. ACS Biomater. Sci. Eng. 2021, 7, 3633–3647. [Google Scholar] [CrossRef] [PubMed]
- Sun, X.Q.; Ma, C.; Gong, W.L.; Ma, Y.A.; Ding, Y.H.; Liu, L. Biological properties of sulfanilamide-loaded alginate hydrogel fibers based on ionic and chemical crosslinking for wound dressings. Int. J. Biol. Macromol. 2020, 157, 522–529. [Google Scholar] [CrossRef] [PubMed]
- Withanage, S.; Savin, A.; Nikolaeva, V.; Kiseleva, A.; Dukhinova, M.; Krivoshapkin, P.; Krivoshapkina, E. Native spider silk-based antimicrobial hydrogels for biomedical applications. Polymers 2021, 13, 1796. [Google Scholar] [CrossRef] [PubMed]
- Zhang, F.; Han, B.; Guo, C.L.; Yang, H.; Wang, J.; Wu, X.C. Fibrous aramid hydrogel supported antibacterial agents for accelerating bacterial-infected wound healing. Mater. Sci. Eng. C 2020, 121, 111833. [Google Scholar] [CrossRef] [PubMed]
- Khan, W.S.; Pyarasani, S.; Asmatulu, R. Reinforcing antibacterial hydrogels through electrospun nanofiber layers for soft tissue engineering. J. Polym. Res. 2020, 27, 380. [Google Scholar] [CrossRef]
- Tao, G.; Wang, Y.J.; Rui, C.; Chang, H.P.; Song, K.; Zuo, H.; Zhao, P.; Xia, Q.Y.; He, H.W. Design and performance of sericin/poly(vinyl alcohol) hydrogel as a drug delivery carrier for potential wound dressing application. Mater. Sci. Eng. C 2019, 101, 341–351. [Google Scholar] [CrossRef] [PubMed]
- Shemesh, M.; Zilberman, M. Structure-property effects of novel bioresorbable hybrid structures with controlled release of analgesic drugs for wound healing applications. Acta Biomater. 2014, 10, 1380–1391. [Google Scholar] [CrossRef]
- Atar-Froyman, L.; Sharon, A.; Weiss, E.I.; Houri-Haddad, Y.; Shvero, D.K.; Domb, A.J.; Pilo, R.; Beyth, N. Anti-biofilm properties of wound dressing incorporating nonrelease polycationic antimicrobials. Biomaterials 2015, 46, 141–148. [Google Scholar] [CrossRef]
- Erdagi, S.I.; Fahanwi, A.N.; Yildiz, U. Genipin crosslinked gelatin-diosgenin-nanocellulose hydrogels for potential wound dressing and healing applications. Int. J. Biol. Macromol. 2020, 149, 651–663. [Google Scholar] [CrossRef]
- Kumar, A.; Kaur, B. Sprayed in-situ synthesis of polyvinyl alcohol/chitosan loaded silver nanocomposite hydrogel for improved antibacterial effects. Int. J. Biol. Macromol. 2020, 145, 950–964. [Google Scholar] [CrossRef] [PubMed]
- Guan, S.M.; Cao, Y.; Xu, Y.Q.; Wang, Y. Preparation and antibacterial property of Ag/AgO/CMCS hydrogel. New Chem. Mater. 2019, 47, 167–171. [Google Scholar]
- Singh, B.; Kumar, A. Graft and crosslinked polymerization of polysaccharide gum to form hydrogel wound dressings for drug delivery applications. Carbohyd. Res. 2020, 489, 107949. [Google Scholar] [CrossRef] [PubMed]
- Wang, W.L.; Yu, W.D. Preparation and characterization of CS-g-PNIPAAm microgels and application in a water vapour-permeable fabric. Carbohyd. Polym. 2015, 127, 11–18. [Google Scholar] [CrossRef] [PubMed]
- Yan, J. Preparation and Applications of Adhesive Antibacterial Hydrogel; Lanzhou University: Lanzhou, China, 2020. [Google Scholar]
- Zhu, X.H.; Huang, C.L.; Wu, L.H.; Li, X.J. Preparation and properties of medical silver ion antibacterial hydrogel dressing. Contemp. Chem. Ind. 2019, 48, 2257–2260. [Google Scholar]
- Chen, L.L.; Qin, Y.; Cheng, J.; Cheng, Y.; Lu, X.L.; Yang, S.X.; Lu, S.H.; Zheng, L.Y.; Cao, Q. A biocompatible PAA-Cu-MOP hydrogel for wound healing. RSC Adv. 2020, 10, 36212–36218. [Google Scholar] [CrossRef] [PubMed]
- Boeva, O.; Antonov, A.; Zhavoronkova, K. Influence of the nature of IB group metals on catalytic activity in reactions of homomolecular hydrogen exchange on Cu, Ag, Au nanoparticles. Catal. Commun. 2021, 148, 106173. [Google Scholar] [CrossRef]
- Ghozali, M.; Restu, W.K.; Triwulandari, E.; Muslih, A. Effect of metal oxide as antibacterial agent on thermoplastic starch/metal oxide biocomposites properties. Polym.-Plast. Technol. Mater. 2020, 59, 1317–1325. [Google Scholar] [CrossRef]
- Velmurugan, P.; Anbalagan, K.; Manosathyadevan, M.; Lee, K.J.; Cho, M.; Lee, S.M.; Park, J.H.; Oh, S.G.; Bang, K.S.; Oh, B.T. Green synthesis of silver and gold nanoparticles using Zingiber officinale root extract and antibacterial activity of silver nanoparticles against food pathogens. Bioprocess Biosyst. Eng. 2014, 37, 1935–1943. [Google Scholar] [CrossRef]
- Rai, M.K.; Deshmukh, S.D.; Ingle, A.P.; Gade, A.K. Silver nanoparticles: The powerful nanoweapon against multidrug-resistant bacteria. J. Appl. Microbiol. 2012, 112, 841–852. [Google Scholar] [CrossRef]
- Lysakowska, M.E.; Denys, A.; Klimek, L.; Sienkiewicz, M. The activity of silver nanoparticles (axonnite) on clinical and environmental strains of Scinetobacter spp. Burns 2015, 41, 364–371. [Google Scholar] [CrossRef]
- Cheng, J.H.; Lv, X.; Pan, Y.Y.; Sun, D.W. Foodborne bacterial stress responses to exogenous reactive oxygen species (ROS) induced by cold plasma treatments. Trends Food Sci. Technol. 2020, 103, 239–247. [Google Scholar] [CrossRef]
- Park, S.B.; White, S.B.; Steadman, C.S.; Pechan, T.; Pechanova, O.; Clmente, H.; Thirumalai, R.V.K.G.; Willard, S.T.; Ryan, P.L.; Feugang, J.M. Silver-coated magnetic nanocomposites induce growth inhibition and protein changes in foodborne bacteria. Sci. Rep. 2019, 9, 17499. [Google Scholar] [CrossRef]
- Tambosi, R.; Liotenberg, S.; Bourbon, M.L.; Steunou, A.S.; Babot, M.; Durand, A.; Kebaili, N.; Ouchane, S. Silver and copper acute effects on membrane proteins and impact on photosynthetic and respiratory complexes in bacteria. mBio 2018, 9, e01535-18. [Google Scholar] [CrossRef]
- Dong, Y.S.; Sun, X.S. Antibacterial mechanism of nanosilvers. Curr. Pharmacol. Rep. 2019, 5, 401–409. [Google Scholar] [CrossRef]
- Heinlaan, M.; Ivask, A.; Blinova, I.; Dubourguier, H.-C.; Kahru, A. Toxicity of nanosized and bulk ZnO, CuO and TiO2 to bacteria Vibrio fischeri and crustaceans Daphnia magna and Thamnocephalus platyurus. Chemosphere 2008, 71, 1308–1316. [Google Scholar] [CrossRef]
- Padmavathy, N.; Vijayaraghavan, R. Enhanced bioactivity of ZnO nanoparticles-an antimicrobial study. Sci. Technol. Adv. Mater. 2008, 9, 35004. [Google Scholar] [CrossRef]
- Jones, N.; Ray, B.; Ranjit, K.T.; Manna, A.C. Antibacterial activity of ZnO nanoparticle suspensions on a broad spectrum of microorganisms. FEMS Microbiol. Lett. 2008, 279, 71–76. [Google Scholar] [CrossRef]
- NeACSu, I.A.; Melente, A.E.; Holban, A.M. Novel hydrogels based on collagen and ZnO nanoparticles with antibacterial activity for improved wound dressings. Rom. Biotechnol. Lett. 2019, 24, 317–323. [Google Scholar] [CrossRef]
- Majumder, S.; Ranjan, D.U.; Yadav, S.; Sharma, P.; Ghosh, D.; Rao, G.K.; Rawat, V. Zinc oxide nanoparticles functionalized on hydrogel grafted silk fibroin fabrics as efficient composite dressing. Biomolecules 2020, 10, 710. [Google Scholar] [CrossRef]
- Baghaie, S.; Khorasani, M.T.; Zarrabi, A.; Moshtaghian, J. Wound healing properties of PVA/starch/chitosan hydrogel membranes with nano Zinc oxide as antibacterial wound dressing material. J. Biomater. Sci. Polym. Ed. 2017, 28, 2220–2241. [Google Scholar] [CrossRef]
- Sunada, K.; Kikuchi, Y.; Hashimoto, K.; Fujishima, A. Bactericidal and detoxification effects of TiO2 thin film photocatalysts. Environ. Sci. Technol. 1998, 32, 726–728. [Google Scholar] [CrossRef]
- Li, Q.L.; Mahendra, S.; Lyon, D.; Brunet, L.; Liga, M.; Li, D.; Alvarez, P.J.J. Antimicrobial nanomaterials for water disinfection and microbial control: Potential applications and implications. Water Res. 2008, 42, 4591–4602. [Google Scholar] [CrossRef]
- Ghosh, M.; Mondal, M.; Mandal, S.; Roy, A.; Chakrabarty, S.; Chakrabarti, G.; Pradhan, S.K. Enhanced photocatalytic and antibacterial activities of mechanosynthesized TiO2-Ag nanocomposite in wastewater treatment. J. Mol. Struct. 2020, 1211, 120876–120891. [Google Scholar] [CrossRef]
- Akhavan, O.; Ghaderi, E. Photocatalytic reduction of graphene oxide nanosheets on TiO2 thin film for photoinactivation of bacteria insolar light irradiation. J. Phys. Chem. C 2009, 113, 20214–20220. [Google Scholar] [CrossRef]
- Xiong, M.H.; Bao, Y.; Yang, X.Z.; Wang, Y.C.; Sun, B.L.; Wang, J. Lipase-sensitive polymeric triple-layered nanogel for“on-demand”drug delivery. J. Am. Chem. Soc. 2012, 134, 4355–4362. [Google Scholar] [CrossRef]
- Tao, Y.; Ju, E.; Ren, J.S.; Qu, X.G. Bifunctionalized mesoporous silica-supported gold nanoparticles: Intrinsic oxidase and peroxidase catalytic activities for antibacterial applications. Adv. Mater. 2015, 27, 1097–1104. [Google Scholar] [CrossRef]
- Huang, W.C.; Tsai, P.J.; Chen, Y.C. Multifunctional Fe3O4@Au nanoeggs as photothermal agents for selective killing of nosocomial and antibiotic-resistant bacteria. Small 2009, 5, 51–56. [Google Scholar] [CrossRef]
- Gopalakrishnan, K.; Ramesh, C.; Ragunathan, V.; Thamilselvan, M. Antibacterial activity of Cu2O nanoparticles on E. coli synthesized from Tridax procumbens leaf extract and surface coating with polyaniline. Dig. J. Nanomater. Biostruct. 2012, 7, 833–839. [Google Scholar]
- Ingle, A.P.; Duran, N.; Rai, M. Bioactivity, mechanism of action, and cytotoxicity of copper-based nanoparticles: A review. Appl. Microbiol. Biot. 2014, 98, 1001–1009. [Google Scholar] [CrossRef]
- He, Y.P.; Ingudam, S.; Reed, S.; Gehring, A.; Srobaugh, T.P.J.; Irwin, P. Study on the mechanism of antibacterial action of magnesium oxide nanoparticles against foodborne pathogens. J. Nanobiotechnol. 2016, 14, 54. [Google Scholar] [CrossRef]
- Leung, Y.H.; Ng, A.M.C.; Xu, X.; Shen, Z.Y.; Gethings, L.A.; Wong, M.T.; Chan, C.M.N.; Guo, M.Y.; Ng, Y.H.; Djurisic, A.B.; et al. Mechanisms of antibacterial activity of MgO: Non-ROS mediated toxicity of MgO nanoparticles towards Escherichia coli. Small 2014, 10, 1171–1183. [Google Scholar] [CrossRef]
- Shchelik, I.S.; Sieber, S.; Gademann, K. Green algae as a drug delivery system for the controlled release of antibiotics. Chem.-Eur. J. 2020, 26, 16644–16648. [Google Scholar] [CrossRef]
- ElFeky, D.S.; Awad, A.R.; Elshobaky, M.A.; Elawady, B.A. Effect of ceftaroline, vancomycin, gentamicin, macrolides, and ciprofloxacin against methicillin-resistant Staphylococcus aureus isolates: An in vitro study. Surg. Infect. 2020, 21, 150–157. [Google Scholar] [CrossRef]
- Chattopadhyay, S.; Raines, R.T. Collagen-based biomaterials for wound healing. Biopolymers 2014, 101, 821–833. [Google Scholar] [CrossRef]
- Bal-Öztürk, A.; Özkahraman, B.; Özbaş, Z.; Yasayan, G.; Tamahkar, E.; Alarçin, E. Advancements and future directions in the antibacterial wound dressings–A review. J. Biomed. Mater. Res. B 2021, 109, 703–716. [Google Scholar] [CrossRef]
- Hu, J.J.; Zheng, Z.; Liu, C.X.; Hu, Q.Y. A pH-responsive hydrogel with potent antibacterial activity against both aerobic and anaerobic pathogens. Biomater. Sci. 2019, 7, 581–584. [Google Scholar] [CrossRef]
- Li, Y.; Cheng, C.; Gao, X.; Wang, S.Y.; Ye, H.H.; Han, X. Aminoglycoside hydrogels based on dynamic covalent bonds with pH sensitivity, biocompatibility, self-healing, and antibacterial ability. J. Appl. Polym. Sci. 2020, 137, 49250. [Google Scholar] [CrossRef]
- Liang, F.Y. Therapeutic Effect and Mechanism of Chitosan-Gentamicin Conjugate on Shrimp Infected by Vibrio parahaemolyticus; Guangdong Ocean University: Zhanjiang, China, 2020. [Google Scholar]
- Zhang, J.J.; Tan, W.Q.; Li, Q.; Liu, X.R.; Guo, Z.Y. Preparation of cross-linked chitosan quaternary ammonium salt hydrogel films loading drug of gentamicin sulfate for antibacterial wound dressing. Mar. Drugs 2021, 19, 479. [Google Scholar] [CrossRef]
- Gupta, P.; Purwar, R. Influence of cross-linkers on the properties of cotton grafted poly(acrylamide-co-acrylic acid) hydrogel composite: Swelling and drug release kinetics. Iran. Polym. J. 2021, 30, 381–391. [Google Scholar] [CrossRef]
- Liao, C.H.; Chen, C.S.; Chen, Y.C.; Jiang, N.E.; Farn, J.C.; Shen, Y.S.; Hsu, M.L.; Chang, C.H. Vancomycin-loaded oxidized hyaluronic acid and adipic acid dihydrazide hydrogel: Bio-compatibility, drug release, antimicrobial activity, and biofilm model. J. Microbiol. Immunol. 2020, 53, 525–531. [Google Scholar] [CrossRef]
- Naeimi, M.; Tajedin, R.; Farahmandfar, F.; Naeimi, M. Preparation and characterization of vancomycin-loaded chitosan/PVA/PEG hydrogels for wound dressing. Mater. Res. Express 2020, 7, 095401. [Google Scholar] [CrossRef]
- Zhou, X.H.; Wei, D.X.; Ye, H.M.; Zhang, X.C.; Meng, X.Y.; Zhou, Q. Development of poly(vinyl alcohol) porous scaffold with high strength and well ciprofloxacin release efficiency. Mater. Sci. Eng. C 2016, 326–335. [Google Scholar] [CrossRef] [PubMed]
- Mukherjee, I.; Ghosh, A.; Bhadury, P.; De, P. Matrix-assisted regulation of antimicrobial properties: Mechanistic elucidation with ciprofloxacin-based polymeric hydrogel against Vibrio species. Bioconjug. Chem. 2018, 30, 218–230. [Google Scholar] [CrossRef] [PubMed]
- Zipperer, A.; Konnerth, M.C.; Laux, C.; Berscheid, A.; Janek, D.; Weidenmaier, C.; Burian, M.; Schilling, N.A.; Slavetinsky, C.; Marschal, M.; et al. Human commensals producing a novel antibiotic impair pathogen colonization. Nature 2016, 535, 511–516. [Google Scholar] [CrossRef]
- Fry, D.E. Antimicrobial peptides. Surg. Infect. 2018, 19, 804–811. [Google Scholar] [CrossRef]
- Zasloff, M. Antimicrobial peptides of multicellular organisms. Nature 2002, 415, 389–395. [Google Scholar] [CrossRef]
- Hancock, R.E.W.; Sahl, H.G. Antimicrobial and host-defense peptides as new anti-infective therapeutic strategies. Nat. Biotechnol. 2006, 24, 1551–1557. [Google Scholar] [CrossRef]
- Mowery, B.P.; Lee, S.E.; Kissounko, D.A.; Epand, R.F.; Epand, R.M.; Weisblum, B.; Stahl, S.S.; Gellman, S.H. Mimicry of antimicrobial host-defense peptides by random copolymers. J. Am. Chem. Soc. 2007, 129, 15474–15476. [Google Scholar] [CrossRef]
- Yeaman, M.R.; Yountn, Y. Mechanisms of anti-microbial peptide action and resistance. Pharmacol. Rev. 2003, 55, 27–55. [Google Scholar] [CrossRef]
- Hancock, R.E.W. Cationic peptides: Effectors in innate immunity and novel antimicrobials. Lancet Infect. Dis. 2001, 1, 156–164. [Google Scholar] [CrossRef]
- Cleophas, R.T.C.; Sjollema, J.; Busscher, H.J.; Kruijtzer, J.A.W.; Liskamp, R.M.J. Characterization and activity of an immobilized antimicrobial peptide containing bactericidal PEG-hydrogel. Biomacromolecules 2014, 15, 3390–3395. [Google Scholar] [CrossRef]
- Dasgupta, A.; Mondal, J.H.; Das, D. Peptide hydrogels. RSC Adv. 2013, 3, 9117–9149. [Google Scholar] [CrossRef]
- Aoki, W.; Kuroda, K.; Ueda, M. Next generation of antimicrobial peptides as molecular targeted medicines. J. Biosci. Bioeng. 2012, 114, 365–370. [Google Scholar] [CrossRef]
- Brogden, K.A. Antimicrobial peptides: Pore formers or metabolic inhibitors in bacteria? Nat. Rev. Microbiol. 2005, 3, 238–250. [Google Scholar] [CrossRef]
- Aye, S.S.S.; Zhang, Z.H.; Yu, X.; Yu, H.D. Silk hydrogel electrostatically functionalized with a polycationic antimicrobial peptide: Molecular interactions, gel properties, and antimicrobial activity. Langmuir 2021, 38, 50–61. [Google Scholar] [CrossRef]
- Baral, A.; Roy, S.; Ghosh, S.; Merino, D.H.M.; Hamley, I.W.; Banerjeeet, A. A peptide-based mechano-sensitive, proteolytically stable hydrogel with remarkable antibacterial properties. Langmuir 2016, 32, 1836–1845. [Google Scholar] [CrossRef]
- Zhou, C.C.; Li, P.; Qi, X.B.; Sharif, A.R.M.; Poon, Y.F.; Cao, Y.; Chang, M.W.; Leong, S.S.J.; Chan-Park, M.B. A photopolymerized antimicrobial hydrogel coating derived from epsilon-poly-L-lysine. Biomaterials 2011, 32, 2704–2712. [Google Scholar] [CrossRef]
- Bai, J.K.; Chen, C.X.; Wang, J.X.; Zhang, Y.; Cox, H.; Zhang, J.; Wang, Y.; Penny, J.; Waigh, T.A.; Lu, J.R.; et al. Enzymatic regulation of self-assembling peptide A9K2 nanostructures and hydrogelation with highly selective antibacterial activities. ACS Appl. Mater. Interfaces 2016, 8, 15093–15102. [Google Scholar] [CrossRef]
- Gunes, O.C.; Albayrak, Z.A. Antibacterial polypeptide nisin containing cotton modified hydrogel composite wound dressings. Polym. Bull. 2021, 78, 6409–6428. [Google Scholar] [CrossRef]
- Atefyekta, S.; Blomstrand, E.; Rajasekharan, A.K.; Svensson, S.; Trobos, M.; Hong, J.; Webster, T.J.; Thomsen, P.; Andersson, M. Antimicrobial peptide-functionalized mesoporous hydrogels. ACS Biomater. Sci. Eng. 2021, 7, 1693–1702. [Google Scholar] [CrossRef]
- Marguerite, R. Chitin and chitosan: Properties and applications. Prog. Polym. Sci. 2006, 31, 603–632. [Google Scholar]
- Hu, Y.; Zhang, Z.Y.; Li, Y.; Ding, X.K.; Li, D.; Shen, C.A.; Xu, F.J. Dual-crosslinked amorphous polysaccharide hydrogels based on chitosan/alginate for wound healing applications. Macromol. Rapid Commun. 2018, 39, e1800069. [Google Scholar] [CrossRef]
- Yu, H.C.; Zhang, H.; Ren, K.F.; Ying, Z.M.; Zhu, F.B.; Qian, J.; Ji, J.; Wu, Z.L.; Zheng, Q. Ultrathin κ-carrageenan/chitosan hydrogel films with high toughness and antiadhesion property. ACS Appl. Mater. Interfaces 2018, 10, 9002–9009. [Google Scholar] [CrossRef]
- Wang, X.Y.; Song, R.J.; Johnson, M.; Aa, S.; He, Z.L.; Milne, C.; Wang, X.Q.; Lara-Sáez, I.; Xu, Q.; Wang, W.X. An injectable chitosan-based self-healable hydrogel system as an antibacterial wound dressing. Materials 2021, 14, 5956. [Google Scholar] [CrossRef]
- Zhang, Y.B.; Dang, Q.F.; Liu, C.S.; Yan, J.Q.; Cha, D.S.; Liang, S.N.; Li, X.L.; Fan, B. Synthesis, characterization, and evaluation of poly(aminoethyl) modified chitosan and its hydrogel used as antibacterial wound dressing. Int. J. Biol. Macromol. 2017, 102, 457–467. [Google Scholar] [CrossRef]
- Chen, K.S.; Ku, Y.A.; Lee, C.H.; Lin, H.R.; Ling, F.H.; Chen, T.M. Immobilization of chitosan gel with cross-linking reagent on PNIPAAm gel/PP nonwoven composites surface. Mater. Sci. Eng. C 2005, 25, 472–478. [Google Scholar] [CrossRef]
- Liu, L.H.; Huang, Y.; Riduan, S.N.; Gao, S.J.; Yang, Y.Y.; Fan, W.M.; Zhang, Y.G. Main-chain imidazolium oligomer material as a selective biomimetic antimicrobial agent. Biomaterials 2012, 33, 8625–8631. [Google Scholar] [CrossRef]
- Rabea, E.I.; Badawy, M.E.T.; Stevens, C.V.; Smagghe, G.; Steurbaut, W. Chitosan as antimicrobial agent: Applications and mode of action. Biomacromolecules 2003, 4, 1457–1465. [Google Scholar] [CrossRef]
- Panpinit, S.; Pongsomboon, S.; Keawin, T.; Saengsuwan, S. Development of multicomponent interpenetrating polymer network (IPN) hydrogel films based on 2-hydroxyethyl methacrylate (HEMA), acrylamide (AM), polyvinyl alcohol (PVA) and chitosan (CS) with enhanced mechanical strengths, water swelling and antibacterial properties. React. Funct. Polym. 2020, 156, 104739. [Google Scholar]
- Wang, F.; Wang, S.G.; Nan, L.P.; Lu, J.W.; Zhu, Z.Q.; Yang, J.T.; Zhang, D.; Liu, J.J.; Zhao, X.; Wu, D.S. Conductive adhesive and antibacterial zwitterionic hydrogel dressing for therapy of full-thickness skin wounds. Front. Bioeng. Biotechnol. 2022, 10, 833887. [Google Scholar] [CrossRef]
- Dai, Z.B.; Zhang, Y.H.; Chen, C.; Yu, F.; Tian, J.; Cai, H.B.; Jiang, X.Z.; Zhang, L.S.; Zhang, W.A. An antifouling and antimicrobial zwitterionic nanocomposite hydrogel dressing for enhanced wound healing. ACS Biomater. Sci. Eng. 2021, 7, 1621–1630. [Google Scholar] [CrossRef]
- Zhu, Y.N.; Zhang, J.M.; Yang, J.; Pan, C.; Xu, T.; Zhang, L. Zwitterionic hydrogels promote skin wound healing. J. Mater. Chem. B 2016, 4, 5105–5111. [Google Scholar] [CrossRef]
- Wang, Y.Q. Modification of Acrylamide Hydrogels and Its Antimicrobial Properties; Anhui University: Hefei, China, 2021. [Google Scholar]
- Yan, X.H.; Zhang, Y.K.; Zhang, H.; Zou, Q.L.; Xing, R.R.; Jiao, T.F. An injectable dipeptide-fullerene supramolecular hydrogel for photodynamic antibacterial therapy. J. Mater. Chem. B 2018, 6, 7335–7342. [Google Scholar]
- Li, H.F.; Yao, Y.; Shi, H.; Lei, Y.L.; Huang, Y.; Wang, K.M.; He, X.X.; Liu, J.B. A near-infrared light-responsive nanocomposite for photothermal release of H2S and suppression of cell viability. J. Mater. Chem. B 2019, 7, 5992–5997. [Google Scholar] [CrossRef]
- Glass, S.; Kühnert, M.; Lippmann, N.; Zimmer, J.; Werdehausen, R.; Abel, B.; Eulenburg, V.; Schulze, A. Photosensitizer-loaded hydrogels for photodynamic inactivation of multirestistant bacteria in wounds. RSC Adv. 2021, 11, 7600–7609. [Google Scholar] [CrossRef]
- Dong, J.C.; Ge, X.D.; Wang, Q.Q.; Wei, Q.F. Preparation and property characterization of cationic photoantimicrobial hydrogrl. J. Mater. Eng. 2019, 47, 56–61. [Google Scholar]
- Truong, V.X.; Li, F.; Forsythe, J. Photolabile hydrogels responsive to broad spectrum visible light for selective cell release. ACS Appl. Mater. Interfaces 2017, 9, 32441–32445. [Google Scholar] [CrossRef]
- Deng, H.L.; Yu, Z.P.; Chen, S.G.; Fei, L.T.; Sha, Q.Y.; Zhou, N.; Chen, Z.T.; Xu, C. Facile and eco-friendly fabrication of polysaccharides-based nanocomposite hydrogel for photothermal treatment of wound infection. Carbohydr. Polym. 2020, 230, 115565. [Google Scholar] [CrossRef]
- Zhou, Q. Research on Preparation and Application of an Intelligent Photosensitive Antibacterial Hydrogel; Guangxi University: Nanning, China, 2020. [Google Scholar]
- Tong, X.Q.; Qi, X.L.; Mao, R.T.; Pan, W.H.; Zhang, M.Y.; Wu, X.; Chen, G.; Shen, J.L.; Deng, H.; Hu, R.D. Construction of functional curdlan hydrogels with bio-inspired polydopamine for synergistic periodontal antibacterial therapeutics. Carbohyd. Polym. 2020, 245, 116585. [Google Scholar] [CrossRef]
- Bu, D.L. Preparation and Antibacterial Properties of Polymer Modified Craphene Oxide and Its Hydrogel Composites; Changchun University of Technology: Changchun, China, 2021. [Google Scholar]
- Abdelgawad, A.M.; Hudson, S.M.; Rojas, O.J. Antimicrobial wound dressing nanofiber mats from multicomponent (chitosan/silver-NPs/polyvinyl alcohol) systems. Carbohyd. Polym. 2014, 100, 166–178. [Google Scholar] [CrossRef]
- Lee, A.L.Z.; Ng, V.W.L.; Wang, W.X.; Hedrick, J.L.; Yang, Y. sericin mixtures as antimicrobial hydrogels for biofilm eradication. Biomaterials 2013, 34, 10278–10286. [Google Scholar] [CrossRef]
- Yang, X. Preparation of Antibacterial Hydrogels Based on Polyvinyl Alcohol (PVA) and Their Properties; University of Science and Technology of China: Hefei, China, 2020. [Google Scholar]
- Palantoken, A.; Sari, M.; Altikatoglu, M.; Tulunay, E.Y.; Eren, T.; Pişkin, S. Dual antimicrobial effects induced by hydrogel incorporated with UV-curable quaternary ammonium polyethyleneimine and AgNO3. Mater. Sci. Eng. C 2016, 68, 494–504. [Google Scholar] [CrossRef]
- Mao, C.Y.; Xiang, Y.M.; Liu, X.; Cui, Z.D.; Yang, X.J.; Yeung, K.; Pan, H.; Wang, X.B.; Chu, P.K.; Wu, S.L. Photo-Inspired antibacterial activity and wound healing acceleration by hydrogel embedded with Ag/Ag@AgCl/ZnO nanostructures. ACS Nano 2017, 11, 9010–9021. [Google Scholar] [CrossRef]
- Yang, S.S.; Zhou, Y.H.; Zhao, Y.Z.; Wang, D.; Luan, Y. Microwave synthesis of graphene oxide decorated with silver nanoparticles for slow-release antibacterial hydrogel. Mater. Today Commun. 2022, 31, 103663. [Google Scholar] [CrossRef]
- Kang, W.W.; Liang, J.C.; Liu, T.; Long, H.; Huang, L.H.; Shi, Q.S.; Zhang, J.X.; Deng, S.P.; Tan, S.Z. Preparation of silane-dispersed graphene crosslinked vinyl carboxymethyl chitosan temperature-responsive hydrogel with antibacterial properties. Int. J. Biol. Macromol. 2022, 200, 99–109. [Google Scholar] [CrossRef]
- Nešović, K.; Mišković-Stanković, V. Silver/poly(vinyl alcohol)/graphene hydrogels for wound dressing applications: Understanding the mechanism of silver, antibacterial agent release. J. Vinyl Addit. Technol. 2022, 28, 196–210. [Google Scholar] [CrossRef]

Publisher’s Note: MDPI stays neutral with regard to jurisdictional claims in published maps and institutional affiliations. |
© 2022 by the authors. Licensee MDPI, Basel, Switzerland. This article is an open access article distributed under the terms and conditions of the Creative Commons Attribution (CC BY) license (https://creativecommons.org/licenses/by/4.0/).
Share and Cite
Liu, J.; Jiang, W.; Xu, Q.; Zheng, Y. Progress in Antibacterial Hydrogel Dressing. Gels 2022, 8, 503. https://doi.org/10.3390/gels8080503
Liu J, Jiang W, Xu Q, Zheng Y. Progress in Antibacterial Hydrogel Dressing. Gels. 2022; 8(8):503. https://doi.org/10.3390/gels8080503
Chicago/Turabian StyleLiu, Jie, Wenqi Jiang, Qianyue Xu, and Yongjie Zheng. 2022. "Progress in Antibacterial Hydrogel Dressing" Gels 8, no. 8: 503. https://doi.org/10.3390/gels8080503
APA StyleLiu, J., Jiang, W., Xu, Q., & Zheng, Y. (2022). Progress in Antibacterial Hydrogel Dressing. Gels, 8(8), 503. https://doi.org/10.3390/gels8080503
